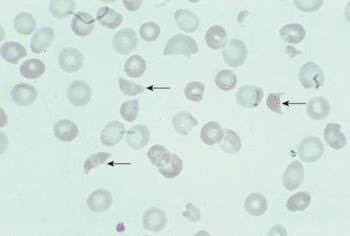

Sources – Anil Ghoms textbook of oral medicine , osmosis.org
Image sources – Google images , researchgate.net










Sources – Anil Ghoms textbook of oral medicine , osmosis.org
Image sources – Google images , researchgate.net









Ps. This is a good case report on Chondroectodermal dysplasia – https://api.semanticscholar.org/CorpusID:5721166
Sources – Shafer’s textbook of oral pathology
Image reference – Shafer’s textbook of oral pathology , semanticscholar.org















Sources – Anil Ghoms textbook of oral medicine , osmosis.org
Image source – researchgate.net , Google images













Sources – Shafer’s textbook of oral pathology
Image source – researchgate.net , Google images













Sources – Shafer’s textbook of oral pathology , slideshare.com
Image source – Google images













Source : Anil Ghoms textbook of oral medicine , Shafer’s textbook of oral pathology
Image source : Google images

































Sources – Shafer’s textbook of oral pathology , slideshare.com
Image source – Google images , researchgate.net








Sources – Shafer’s textbook of oral pathology
Image source – Google images












Sources – Shafer’s textbook of oral pathology , osmosis.org
Image source – Google images

Source – Anil Ghoms textbook of oral medicine
Image source – Google images